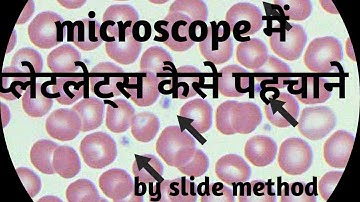
Microscopic platelets count by slide method

⬇ DOWNLOAD NOW
Kalau muncul iklan pop-up, tutup lalu klik tombol kembali
Download lagu Platelet count by simple manually slide method || Hematology secara gratis hanya untuk keperluan promosi. Dukung artis favorit kamu dengan membeli musik original di iTunes atau platform resmi lainnya.
 Platelet count of Blood #hereditybioacademy #reels
Platelet count of Blood #hereditybioacademy #reels
 Complete blood count Slide With Normal platelets under microscope 🔬
Complete blood count Slide With Normal platelets under microscope 🔬
 Manual platelet count - hemocytometer Procedure | Calculation | interpretation
Manual platelet count - hemocytometer Procedure | Calculation | interpretation
 Making a peripheral blood smear | blood smear preparation | prepare a perfect blood smear|Hematology
Making a peripheral blood smear | blood smear preparation | prepare a perfect blood smear|Hematology
 Platelets manual counting by blood smear explained easily in Urdu & Hindi.How platelet seen in slide
Platelets manual counting by blood smear explained easily in Urdu & Hindi.How platelet seen in slide
 Manual Platelet Count - Slide Method
Manual Platelet Count - Slide Method
 Microscope| platelets DLC #platelets #cbc #shorts #youtubeshorts
Microscope| platelets DLC #platelets #cbc #shorts #youtubeshorts
Microscopic platelets count by slide method
Microscopic platelets count by slide method